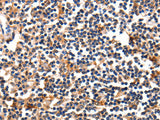
FADD Polyclonal Antibody Store at -20°C

FADD Polyclonal Antibody Store at -20°C
SKU: E-AB-10318-200
FADD Polyclonal Antibody Store at -20°C
| SKU # | E-AB-10318 |
| Reactivity | Human, Mouse |
| Host | Rabbit |
| Applications | WB, IHC |
Product Details
| Isotype | IgG |
| Host | Rabbit |
| Reactivity | Human, Mouse |
| Applications | WB, IHC |
| Clonality | Polyclonal |
| Immunogen | Recombinant protein of human FADD |
| Abbre | FADD |
| Synonyms | FADD, FADD protein, FAS-, Fas (TNFRSF6) associated via death domain, Fas TNFRSF6 associated via death domain, Fas associated via death domain, Fas associating death domain containing protein, Fas associating protein, Fas associating protein with death domain |
| Swissprot | |
| Calculated MW | 23 kDa |
| Cellular Localization | Cytosol, ripoptosome, Nucleus, Plasma Membrane, CD95 death-inducing signaling complex, death-inducing signaling complex, plasma membrane, Other locations: cell body, cytoplasm, membrane raft, neuron projection. |
| Concentration | 0.5 mg/mL |
| Buffer | Phosphate buffered solution, pH 7.4, containing 0.05% stabilizer and 50% glycerol. |
| Purification Method | Affinity purification |
| Research Areas | Cancer, Cell Biology |
| Conjugation | Unconjugated |
| Storage | Store at -20°C Valid for 12 months. Avoid freeze / thaw cycles. |
| Shipping | The product is shipped with ice pack,upon receipt,store it immediately at the temperature recommended. |
Related Reagents
| Applications | Recommended Dilution |
| WB | 1:1000-1:5000 |
| IHC | 1:50-1:100 |
Background
The protein encoded by this gene is an adaptor molecule that interacts with various cell surface receptors and mediates cell apoptotic signals. Through its C-terminal death domain, this protein can be recruited by TNFRSF6/Fas-receptor, tumor necrosis factor receptor, TNFRSF25, and TNFSF10/TRAIL-receptor, and thus it participates in the death signaling initiated by these receptors. Interaction of this protein with the receptors unmasks the N-terminal effector domain of this protein, which allows it to recruit caspase-8, and thereby activate the cysteine protease cascade. Knockout studies in mice also suggest the importance of this protein in early T cell development.